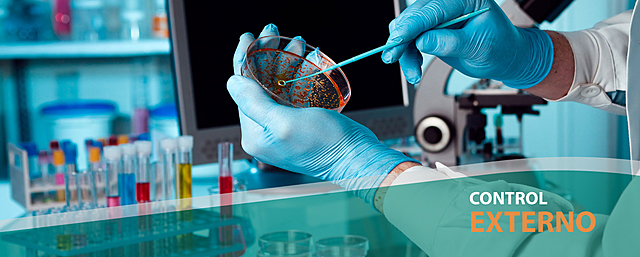
Control de Calidad Externa

-
El ser humano habitaba en cuevas que le ofrecieran refugio y protección contra los efectos adversos del clima y las bestias, vivía únicamente de la recolección y su única labor era seleccionar aquellos productos que requería para su sobrevivencia.
-
El hombre empezó a fabricar sus primeros utensilios, consistentes en vasijas, herramientas y armas, las cuales le permitieron elaborar algunos artículos que eran de utilidad para su sustento y vestimenta. Aquí fue donde propiamente inició la calidad.
-
El hombre comenzó a practicar la agricultura para obtener sus propios alimentos. En esta época establecieron sus primeras viviendas.
-
La administración de la calidad surge como un proceso para mejorar el conocimiento y la posición del hombre. El hombre se da cuenta que a medida que mejoran las armas y utensilios, también mejora la obtención de alimentos
-
“si un constructor construye una casa y no lo hace con buena resistencia y la casa se derrumba y mata a los ocupantes, el constructor debe ser ejecutado”.
-
El control de la calidad se llevaba por medio de 2 organizaciones, una dedicada a la normalización y establecimiento de estándares de calidad y la otra a la productividad.
-
En esta época nació la capacitación de los artesanos, buscando que éstos aprendieran más y mejores destrezas en sus labores.
-
Comenzó la comercialización y la competencia, los fenicios utilizaban un programa correctivo para asegurar la calidad, el cual consistía en cortarle la mano al responsable de una mala calidad.
-
Se comenzó a ponerles marcas a los productos, con lo cual los clientes podían identificar aquellos artículos de buena calidad
-
Las fábricas reemplazaron a los talleres, el énfasis se centraba en la fabricación masiva de artículos en serie, restándole importancia a la calidad de los mismos.
-
En Estados Unidos logró aumentar en forma significativa los niveles de productividad mediante la observación de tiempos y movimientos de los empleados, con lo cual se crearon los departamentos de calidad con esa finalidad.
-
Aparecieron entonces los primeros inspectores de tiempo completo y al control de calidad se le denominó control de calidad por inspección.
-
Aplicó el control estadístico de procesos (CEP), exitosamente en los laboratorios de Bell Telephone, con sus gráficos de control.
-
Se comenzaron a utilizar procedimientos estadísticos de muestreo para la producción de armamento, poniendo como objetivos fundamentales la eficacia de las armas, la mayor cantidad producida de las mismas y en un tiempo mínimo.
-
Dió conferencias a ingenieros Japoneses sobre métodos estadísticos y sobre la responsabilidad de la calidad. Se basa en 14 puntos en donde se incluyen, la mejora continua, propósito constante y conocimiento profundo
-
Visitó Japón y destacó para la capacitación del personal en gestión para calidad. Los japoneses fijaron normas de calidad que después se adaptaron en todo el mundo
-
Se crea el Centro Nacional de Productividad. Se contratan los servicios de expertos en técnicas de productividad, que pertenecen al methods Engineering Council.
-
Creó el movimiento cero defectos en Martin-Marietta promoviendo hacer las cosas correctas desde el principio.
-
Organizó la primera conferencia de control de calidad para supervisores, enfocada a todos aquellos supervisores operativo.
-
En Estados Unidos, Se funda el Comité de Costos de la Calidad (ASQ) que destaca la magnitud e importancia que tiene la calidad del producto en el bienestar de un negocio de fabricación
-
El Centro Industrial de Productividad impartió los cursos para la “Formación de Consultores”, para profesionales de la Ingeniería, la economía y la contabilidad.
-
Fue el inicio de lo que se le llama "El milagro Japonés"
-
su misión es la de generar y difundir tecnología para la capacitación adecuada a las características de la cultura mexicana.
-
Gran Bretaña
-
-
El profesor Donald Dewar, desarrollo un sistema de capacitación paralos circulos de calidad, fundando el "Quality Circule Insitute" y rápidamente en muchas empresas norteamericanas como IBM, Metaframe Cop fueron adoptados con magnificos resultados.
-
La International Sdandard Organization (ISO) publica la ISO9000.
Por entonces algunos países tuvieron la oportunidad de alinear sus propias normas nacionales con la norma ISO final. -
Escribió, el best seller, La calidad es libre
-
México, Nace el grupo “Desarrollo Calidad de Vida” con 19 integrantes
-
Inglaterra, es el primer país del mundo que lanza una Campaña Nacional de Calidad.
-
Se crea la Fundación Mexicana para la Calidad Total. Se convierte en “La Voz de Calidad en la Calidad”. El ING. Julio Gutiérrez es su primer presidente.
-
-
oficina dependiente de la SECOFI, sus objetivos son:
- Fomentar y estimular los procesos de calidad total.
- Promover la productividad y la calidad de los productos.
- Fomentar las exportaciones.
-
Variación biológica Individual
-
-
Looking for a timeline maker?
Create timelines for projects, roadmaps, history, lessons, legal cases, and stories with Timetoast. Timetoast is a timeline maker for work, school, research, and stories.